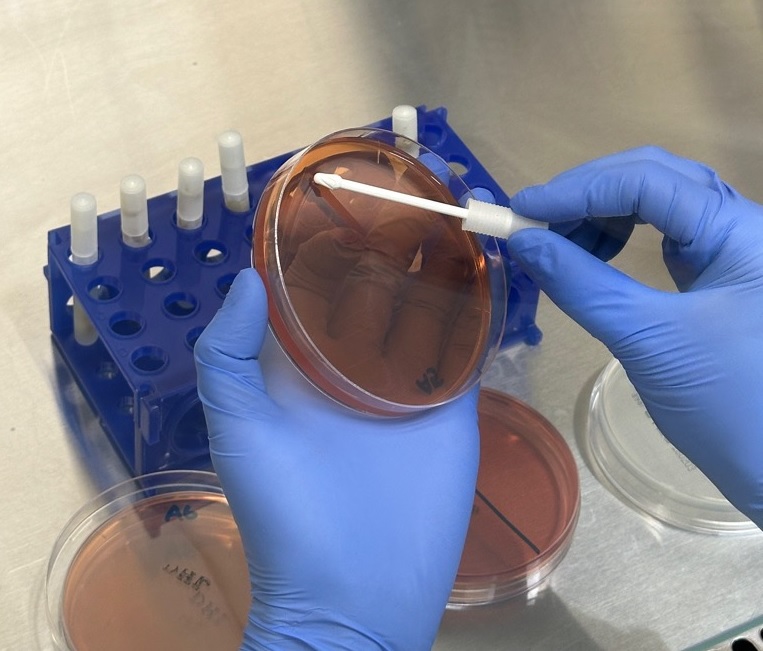

保健所検査課【保菌検査】
登録日:2026年4月6日
ホーム検査受付飲用水検査浴槽水検査食品検査業務紹介(微生物)業務紹介(理化学)よくある質問
保菌検査について
⒈ 検査項目
(1)細菌検査
次の5項目を1セットとして検査を受け付けています。
-
赤痢菌
- チフス菌
- パラチフス菌
- サルモネラ
- 腸管出血性大腸菌(O157、O26等を含む)
(2)ウイルス検査
次の1項目の検査を受け付けています。
- ノロウイルス
⒉ 検査のご依頼者
- どなた様でもご依頼可能です。
- 水道工事に従事される方や給食・食品製造に従事される方などからご依頼いただいております。
⒊ 検査手数料
検体をお持ちになった際にお支払いいただきます。
- 細菌検査(5項目) : 1,600円
- ウイルス検査(ノロウイルス) : 13,410円
⒋ 申し込み方法
- 検査依頼書と採水容器をお渡ししますので、平日の8時30分から17時の間に一度、保健所検査課(4階)までお越し下さい。
※予約の必要はありません。
※検査希望の方が10名以上の場合は、お越しいただく前にお電話いただけると手続きがスムーズとなります。
- 採便後、検査受付日(原則、月~水曜日)の8時30分から15時までの間に、検査依頼書・採水容器・検査手数料を保健所検査課(4階)にお持ち下さい。
※検査受付日は決まっておりますので、次の「保菌検査受付日(令和8年度)」をご確認ください。
⒌ 結果の通知
- 通常、ご依頼のあった週内に郵送(投かん)となります。
※郵送の都合上、同一週内にお手元に届かない場合があります。
※窓口でのお受け取りをご希望の場合は、検査申込時にお伝えください。

⒍ 注意事項
- 採便はできるだけ当日に行ってください。前日に採取した場合は、室温で保管してください。
- 採便量が不足の場合、検査できないことがあります。外装に記載の採取方法をお読みのうえ、採便してください。
このページに関するお問い合わせ先
保健福祉部 保健所検査課
電話番号: 0246-27-8598 ファクス: 0246-27-8601





